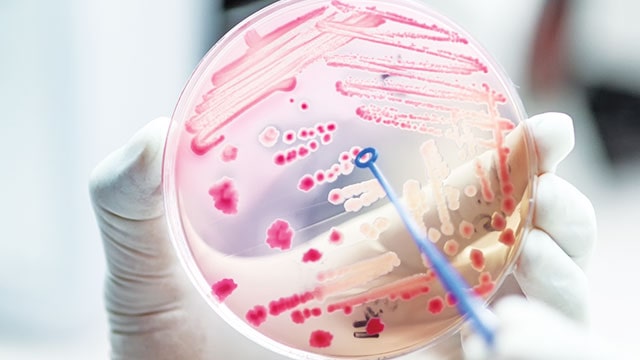

Resistensi Antimikroba atau (Antimicrobial Resistance/AMR) telah menjadi masalah kesehatan masyarakat dunia. Laporan World Health Organization (WH0) pada 2014 menyatakan permasalahan ini merupakan ancaman serius bagi kesehatan masyarakat termasuk di Indonesia. AMR berakar dari penggunaan antimikroba yang tidak bijak dan berujung pada tidak efektifnya terapi antimikroba. Kali ini, pakar dan aktivis Lembaga Swadaya Masyarakat (LSM) membabarkan keterkaitan AMR dan penggunaan antibiotik pada hewan ternak.
Jakarta (Greeners) – Direktur Kesehatan Lingkungan, Kementerian Kesehatan (Kemenkes) dr. Imran Agus Nurali, Sp.KO mengatakan pemakaian antibiotik yang tidak rasional bukan hanya terjadi di bidang kesehatan manusia tapi juga di bidang kesehatan hewan dalam hal ini peternakan dan perikanan. Penggunaannya untuk mengobati hewan, mencegahnya dari penyakit, dan meningkatkan pertumbuhan hewan. AMR pun menjadi masalah kesehatan yang tidak lepas dari kesejahteraan hewan ternak.
“Hampir semua antibiotik manusia juga digunakan di bidang peternakan. Penyalahgunaan dalam penambahan makanan hewan memiliki konsekuensi penting bagi kesehatan masyakarat karena dapat menyebabkan bakteri kebal antibiotik melalui konsumsi makanan, kontak langsung dengan makanan hewan atau melalui lingkungan,” ujarnya pada webinar Saat Angka Penyebaran Covid-19 Masih Tinggi, Ancaman “Superbug” Ada di Depan Mata, Selasa (17/11/2020).
Kemenkes: Pengurangan Antibiotik pada Hewan Ternak Salah Satu Solusi AMR
Kuman yang kebal atau resisten terhadap antibiotik, lanjut Imran, menjadikan penyakit lebih awet. Hal ini meningkatkan angka kematian dengan biaya yang meningkat tajam. Dalam perkembangannya AMR telah menjadi salah satu ancaman terbesar pada abad ke-21 ini.
Imran lalu mengutip penelitian pakar ekonomi terkemuka yang mengaji dampak ekonomi seputar AMR. Penelitian ini memerkirakan 700 ribu kematian setiap tahun akibat AMR. Selain itu, kegagalan penanganan AMR menyebabkan 10 juta kematian setiap tahun. Peneliti memprediksi jumlah kematian ini akan memakan biaya hingga US$100 triliun pada 2050. Menyadari dampak kesehatan dan ekonomi yang sedemikian besar dari penggunan antibiotik yang kurang tepat, WHO menyepakati global action plan untuk menangani AMR pada World Health Essembly Mei 2018.
“Pengaturan penggunaan antibiotik pada makanan hewan merupakan bagian penting bagi program mengatasi AMR. Lintas sektor terkait mempertimbangkan agar menghilangkan penggunaan antibiotik sebagai pemaju pertumbuhan,” kata Imran.
LSM Desak Pemerintah Tingkatkan Standar Kesejahteraan Hewan Ternak
Sementara itu, Ketua Pengurus Harian YLKI, Tulus Abadi, menyampaikan AMR merupakan ancaman serius bukan cuma masalah obat antibiotik saja. Menurut Tulus, AMR juga persoalan residu antibiotik pada hewan ternak dan tanaman. Konsumen, lanjut Tulus, mengonsumsi dua hal yang terakumulasi ke tubuh hingga pada akhirnya tumbuh resistensi sangat serius. Salah satu contoh resistensi yakni pada penderita Tuberkulosis.
“Banyak sekali peternak menggunakan antibiotik, khususnya ayam. Belum lagi kalau penggunaan antibotiknya itu ilegal atau sisa-sisa dari manusia maupun rumah sakit. Ini menjadi ancaman ganda. Kita mengonsumsi antibiotik dengan pola yang tidak benar, dan sepiring makanan yang tersedia di meja makan kita ada potensi residu antibiotik,” ujar Tulus.
Pada kesempatan yang sama, Juru Kampanye World Animal Protection (WAP) Indonesia, Rully Prayoga, menyatakan pemerintah Indonesia mesti segera membenahi perilaku pengusaha. Guna mencegah masalah AMR yang lebih dalam, pemerintah harus mengevaluasi perilaku pengusahan peternakan terhadap hewan ternak. Salah satu hal yang harus menjadi perhatian yakni penerapan batas pemakaian antibiotik bagi hewan ternak.
“Pemerintah Indonesia khususnya Kementerian Pertanian perlu meningkatkan standar kesejahteraan hewan, serta memantau dan melaporkan penggunaan antibiotik pada hewan ternak. Retailer, supermarket, dan restoran cepat saji harus menetapkan standar yang jauh lebih tinggi untuk memastikan hewan dalam rantai pasokan mereka diperlakukan dengan baik, dan antibiotik digunakan secara bertanggung jawab dalam peternakan,” kata Rully.
LSM: Kesejahteraan Hewan Kunci Perangi AMR
WAP menyerukan pemerintah untuk mengakhiri pabrik peternakan. Selain itu, WAP juga mendesak pengurangan produksi dan konsumsi produk hewan ternak untuk semua sisa produksi hewan ternak. Rully pun menekankan pentingnya memastikan kesejahteraan hewan yang tinggi di Indonesia.
Yayasan Lembaga Konsumen Indonesia bersama dengan WAP meminta Kementerian Pertanian untuk lebih serius dalam melakukan pengawasan terhadap pengggunaan antimikrobakteri pada hewan khususnya ayam untuk melindungi konsumen agar terbebas dari dampak penggunaan antibiotik yang berlebihan.
“Kami menyerukan kepada bisnis retailer, restoran cepat saji seperti KFC dan McDonald’s untuk menerapkan standar kesejahteraan hewan terutama pemberian antibiotik. Pemerintah Indonesia dan sektor peternakan secara umum mesti menghentikan penggunaan antibiotik secara berlebihan dan menghindari pandemi di masa depan yang disebabkan oleh resistensi bakteri antimikroba,” ujar Rully.
Baca juga: Hari Toilet Sedunia, Praktisi Soroti Pengelolaan Air Limbah Domestik
AMR: Survei Temukan 81,4 persen Peternak Gunakan Antibiotik pada Hewan Ternak
World Economic Forum (Weforum) memperkirakan konsumsi antibiotik hewan global pada 2013 sekitar 131.000 ton. Secara relatif. Penggunaan antibiotik pada ternak dan manusia serupa, rata-rata 118 mg/kg dan 133 mg/kg. Namun, karena total biomassa ternak jauh melebihi biomassa manusia, Weforum memperkirakan total penggunaan antibiotik untuk manusia jauh lebih rendah, yakni sekitar 40.000 ton pada tahun 2013. Artinya penggunaan antibiotik pada ternak kemungkinan besar mencakup sekitar 70-80 persen konsumsi total.
Sementara itu di Indonesia –menurut Survei Kementerian Pertanian pada tahun 2017– 81,4 persen peternak menggunakan antibiotik pada unggas untuk pencegahan penyakit; 30,2 persen peternak menggunakan antibiotik untuk pengobatan; dan 0,3 persen masih menggunakannya untuk promosi pertumbuhan.
Survei juga menemukan colistin –antibiotik yang bukan untuk mengobati infeksi serius dalam pengobatan manusia karena sangat beracun– menyumbang 34 persen dari semua antibiotik yang peternak gunakan sebagai profilaksis atau untuk pengobatan unggas mereka. Antibiotik ini menyebabkan resistensi antibiotik dan masalah kesehatan masyarakat.
Pemerintah Indonesia telah mengeluarkan peraturan pelarangan colistin melalui Peraturan Menteri Nomor 09160 / PK.350 / F / 12/2019. Menurut FAO, Indonesia termasuk lima negara dengan proyeksi persentase peningkatan konsumsi antimikroba terbesar pada tahun 2030. Kelima negara dari 50 negara dengan jumlah antimikroba terbesar untuk peternakan pada 2010 termasuk Myanmar (205%), Indonesia (202%), Nigeria (163%), Peru (160%), dan Vietnam (157%).
Penulis: Dewi Purningsih
Editor: Ixora Devi